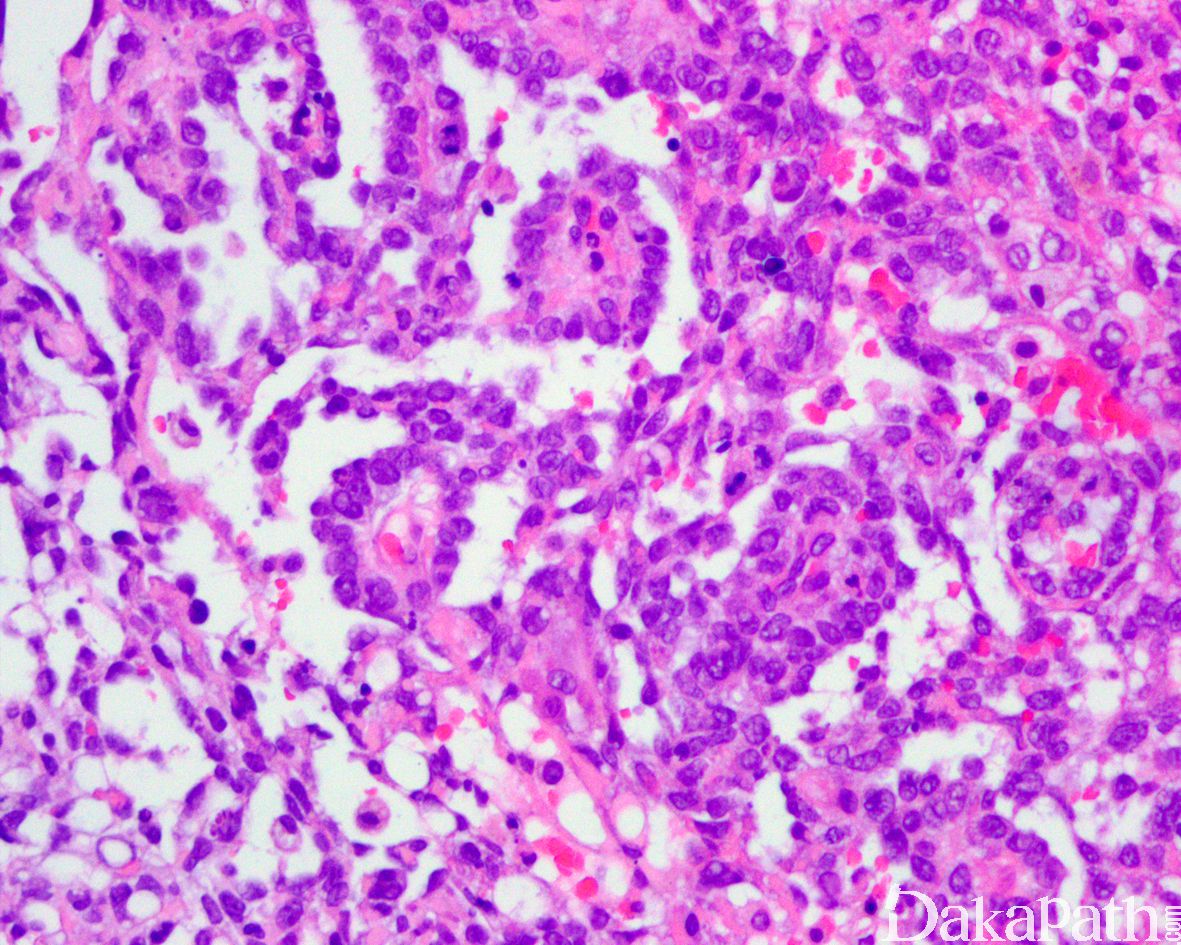

睾丸青春期前型卵黄囊瘤
Testicular Prepubertal-Type Yolk Sac Tumour
概述:
一种生殖细胞肿瘤,有卵黄囊、尿囊及胚胎外间充质分化,与青春期后型不同,青春期后型卵黄囊瘤与原位生殖细胞肿瘤相关。
发病部位: 睾丸
诊断要点:
- 发病年龄 3 个月至 8 岁,是青春期前睾丸最常见的睾丸肿瘤(48%-62%)。大体检查实性为主,切面均质,黄色-棕色结节状,可有局灶囊性变,出血坏死不常见;
- 组织学及免疫表型和青春期后型卵黄囊瘤相似,两个显著不同点为:与小管内生殖细胞肿瘤无关,周围睾丸实质无原位生殖细胞肿瘤或相关的证据(青春期后型卵黄囊瘤与原位生殖细胞肿瘤相关),大多数为纯型卵黄囊瘤(偶尔可伴有畸胎瘤),而青春期后型卵黄囊瘤罕见为纯型,大多数是混合性生殖细胞肿瘤的组成成分。

免疫组织化学染色:
Cytokeratin、AFP、glypican-3. SALL4. PLAP 及 SOX17 均阳性;CD30(BerH2)、podoplanin (D2-40)、OCT3/4. CD117. hCG、NANOG、EMA、inhibin-α 及 calretinin 均阴性。
分子标记:
无 i12p
鉴别诊断:
睾丸幼年型粒层细胞瘤 :常发生于 6 个月以内幼儿,大体检查常见多个囊腔,镜下以小叶状或结节状生长为主,由明显的纤维肌性间质分隔;可见滤泡样结构,内容嗜酸性分泌物,囊腔被覆 1 层或多层多角形瘤细胞。免疫组化染色 AFP 阴性,inhibin 阳性。
预后:
较好,纯的青春期前型卵黄囊瘤存活率将近 100%
治疗:
睾丸切除,复发和转移的肿瘤采用化疗。
参考文献:
Testicular and paratesticular neoplasms in prepubertal males.
Agarwal PK, Palmer JS.
J Urol. 2006 Sep;176(3):875-81. Review.
Ulbright TM.
Mod Pathol. 2005 Feb;18 Suppl 2:S61-79. Review.
